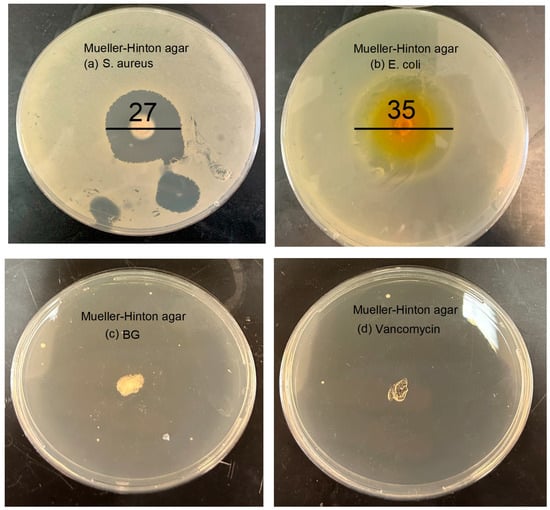

Abstract
Bacterial infections caused by biofilms are often difficult to treat due to the resistant nature of the latter, which require high concentrations of antibiotics to be applied for prolonged periods to achieve complete eradication. This study aimed to design a new drug delivery system for long-term drug release for the treatment of bacterial infections. Specifically, bioactive glass preloaded with vancomycin (BG-V) and synthesized without any thermal treatment was designed to load higher percentages of the drug and release it slowly over time. In this study, BG-V was-synthesized using a solution containing vancomycin, with glass being formed around it by adding metal precursors to this solution. The BG-V was then left to dry at room temperature to form a white powder with vancomycin trapped in the structure. The successful synthesis of BG-V was confirmed by X-ray diffraction, Fourier-transform infrared spectroscopy, scanning emission microscopy, and nitrogen adsorption–desorption analysis. The results showed that BG-V was successfully developed using FTIR, showing vancomycin within the BG-V structure. After the drug release, BG-V showed great bioactivity, as indicated by the XRD and bacterial studies. The result shows that drug release is controlled by a combination of diffusion through the matrix and the gradual erosion of the delivery system.
1. Introduction
Bioactive glass (BG) has emerged as a prominent biomaterial, gaining a lot of attention in this field due to its favourable characteristics including versatility, bioactivity, ease of synthesis, cost-effectiveness, and application in regenerative medicine and drug delivery [1]. BG can be synthesized through melt-quenching, the sol–gel process [2], flame synthesis [3], and microwave-assisted synthesis [4,5]. Each method results in a BG with unique properties that can be used for different applications. Sol–gel BG has gained a lot of interest due to its higher porosity, increased surface area, and highly customizable compositions compared to melt-quench BG [4]. This leads to improved bioactivity as the increased surface area allows for more rapid ion exchange with biological fluids and the formation of an apatite-like layer on its surface [6,7]. Specifically, the tertiary system of SiO2-CaO-P2O5 is one of the most widely utilized and studied BG systems due to its versatility and adaptability in various biomedical applications [8]. This versatility can be attributed to the glass composition, which combines network formers, like SiO2 and P2O5, and establishes the silicate–phosphate structure with network modifiers, such as CaO, which enhance both the bioactivity and mechanical properties [9,10]. Typically, the synthesis of BG involves high thermal treatment to remove organics and nitrates [8]. However, recent studies have reported the successful synthesis of bioactive glass without the need for thermal treatment [11,12]. This expands the uses and applications of bioactive glass to include preloaded drugs. This study will investigate the synthesis of BG preloaded with antibiotics and evaluate its sustained drug delivery potential for treating infections, particularly biofilm-associated infections that develop on prosthetics following joint replacement surgeries.
Biofilms are bacterial colonies that are protected by a self-produced polymeric matrix that can invade inert or living surfaces [13]. These colonies require prolonged antimicrobial exposure above the minimum inhibitory concentration (MIC). A drug delivery system that aims to treat these infections needs to load enough antibiotics to deliver them over a period of at least a month with minimal burst release to not cause any toxicities locally at the infection site [13]. BG can be designed to load antibiotics during synthesis to deliver them over an extended period as the matrix gradually degrades, making them ideal for the treatment of biofilm and biofilm-related infections. Vancomycin, a glycopeptide antibiotic, is often the antimicrobial of choice when treating these biofilm infections as it has proven to be effective in penetrating the biofilm matrix. Vancomycin acts by binding to cell precursors that are essential for the integrity of cell wall development, which is effective in killing bacterial cells [14]. The choice of antibiotic that surgeons make when trying to treat biofilms is due to the antibiotic’s familiarity and common use, the number of pathogens it can attack, and its successful release from bone cement [15].
Vancomycin incorporation into BG has traditionally been achieved through post-synthesis depletion methods, with varying degrees of success. This approach involves immersing BG particles in drug solutions of different concentrations, with loading efficiency determined by UV-Vis spectroscopy measurements before and after immersion. Previous studies have demonstrated a wide range of loading efficiencies, heavily influenced by BG composition, synthesis methods, and templating techniques. Highly porous mesoporous bioactive glasses (MBGs) have shown antibiotic loading efficiencies ranging from 50 to 90%, with release durations spanning from a few hours to over 25 days [13]. Anand et al. reported loading efficiencies of approximately 40% for Ceftriaxone and sulbactam sodium in MBGs [16], while Xia et al. achieved 36–48% loading efficiency for gentamicin [17]. This study aims to enhance antimicrobial loading, specifically vancomycin, by incorporating the drug during the BG synthesis process. This approach is expected to promote stronger chemical interactions between vancomycin molecules and the BG matrix, potentially improving loading efficiency and releasing kinetics.
When BG is loaded with any drug, chemical bonds are expected to form between BG and the drug of choice based on their chemical structures. The interactions will strongly affect the encapsulation efficiency of the drug and subsequent release. For this study, vancomycin was chosen for the reasons previously stated. When BG is loaded with vancomycin there is a high potential of hydrogen bonds forming between the two. This is primarily due to the presence of multiple functional groups in vancomycin’s structure, such as amide, carboxyl, and hydroxyl groups [18], as shown in Figure 1a, which can interact with the silanol groups (Si-OH) on the surface of the BG, as shown in Figure 1b. These hydrogen bonds are stronger than simple physical adsorption forces, resulting in vancomycin being held more tightly within the BG matrix compared to surface adsorption alone.

Figure 1.
Structure of (a) vancomycin molecule and (b) bioactive glass structure [19].
This study aims to establish the ability of BG to load drugs during synthesis and its bioactivity and biocompatibility in vitro when it is synthesized without thermal treatment. BG is a versatile biomaterial that can be used in various applications including bone regeneration and drug delivery. BG properties such as porosity surface chemistry and degradation rate are highly influenced by the synthesis method. These properties can be tailored differently based on the application, enabling the customization and the creation of application-specific biomaterial.
2. Materials and Methods
2.1. Materials
The synthesis involved using a silicon source, which was tetraorthosilicate (TEOS), a phosphate source, tetraethyl phosphate (TEP), and a calcium source, calcium nitrate tetrahydrate (CaN). All the reactions were carried out in ethanol (Sigma-Millipore, Oakville, ON, Canada) and Millipore ultrapure water. For the drug release studies, phosphate-buffered saline (PBS) was prepared by dissolving commercial tablets (Sigma-Millipore, Oakville, ON, Canada) in Millipore ultrapure water. Vancomycin hydrochloride (sterile, USP-grade for IV injection) was used for the drug release studies. All chemicals used were purchased from Sigma-Millipore (Oakville, ON, Canada) and used as received without further purification or modification.
2.2. Synthesis Procedure
A solution of ethanol, hydrochloric acid, and water (20 g) was prepared at room temperature, with a 10:5:1 ratio, to ensure hydrolysis and condensation control. Vancomycin was dissolved in a small amount of water and added to the solution to make different final concentrations of 2.5 mg/mL, 5 mg/mL, and 10 mg/mL. TEOS (6.7 g) was then added dropwise under continuous stirring, followed by a one-hour interval to allow hydrolysis. Calcium nitrate tetrahydrate (1.4 g) was dissolved in a small amount of water and then added, and the solution was stirred for an additional hour. TEP (0.73 g) was then added dropwise, and the mixture was stirred overnight at 200 rpm to complete gelation. The resulting gel was then transferred to Petri dishes and dried at room temperature for 24–48 h to avoid vancomycin degradation. Finally, the final powder was ground and sieved to ensure a uniform particle size.
2.3. Characterization of Samples
X-ray diffraction (XRD) and Fourier-transfer infrared spectroscopy (FTIR) were used to determine the structure of the BG-Van after synthesis. A sample of the BG-Van was analyzed using a MiniFlex 600 diffractometer (Rigaku Corporation, Tokyo, Japan), which collected X-ray dispersive patterns under Cu Kα radiation (40 kV, 15 mA) to determine crystallinity. Measurements were taken between 10 and 60 °C at increments of 2 °C. For FTIR, a Cary 630 spectrometer (Agilent, Santa Clara, CA, USA) was used to assess molecular vibrations using the KBr pellet method from 4500 to 400 cm−1 for the synthesized powder. Pore analysis including surface area, pore size, and pore diameter were determined using the BET method, which was carried out using a TriStar 3000 porosimeter (Micromeritics, Norcross, GA, USA). Samples of 0.1 g were used for analysis, with each sample degassed at 100 °C for 12 h to clear up the pores and allow for accurate measurements. Also, the surface of the powder was analyzed via SEM using a JSM-6380LV (JEOL, Tokyo, Japan), where the samples were coated with gold to improve electronic conductivity. The same instrument was used to perform EDX analysis to investigate the elemental composition of the synthesized glass.
2.4. Drug Release
Glass samples of 10 mg were immersed in 10 mL of phosphate-buffered saline (PBS) at pH 7.4, which is physiological pH, in plastic tubes. The tubes were incubated in a shaker at 37 °C with continuous stirring to mimic the physiological condition until drug release reached 100%. Samples of 2 mL were collected at 30 min intervals and then 1-day intervals, and analyzed using UV-visible spectroscopyn (Thermo Fisher Scientific, Madison, WI, USA) to determine the released drug concentration. The removed volume was replenished with an equal volume of fresh PBS solution to maintain sink conditions.
BG-V drug release data were fitted to various mathematical models [20,21] and the to determine the predominant release kinetics. The models applied in this study include the following:
Zero-order model: This model suggests a uniform drug release rate independent of concentration. The following equation is used to calculate zero-order fit:
where Ct and C0 are the amount of drug dissolved at time t, and the initial amount of drug in solution, respectively. k is the zero-order rate constant.
First-order model: Where the drug release rate is directly proportional to the remaining concentration, showing a linear concentration-dependent relationship. It is calculated using this equation:
Which can also be expressed as follows:
where C0 is the initial drug concentration and k describes the first-order rate constant.
Higuchi model: This describes the drug release from matrix systems based on diffusion. The following equation is used to calculate the fit:
Q refers to the amount of drug released at time t. A is the area, the drug initial concentration is C, and Cs describes the drug solubility. D refers to the diffusivity of the drug [22].
The Higuchi model can be simplified to describe drug release from matric and polymeric systems as follows:
where Mt/ represents the cumulative amount of drug released at time t, and k is the Higuchi constant.
Korsmeyer–Peppas: This is a model that combines diffusion and erosion effects and can be calculated using the following equation:
where Mt/ is the cumulative amount of drug released at time t, k’ is the kinetic constant, and n is usually used to describe a specific diffusion mechanism. In order to describe the diffusion mechanism of the system determined by the exponent, “n” is used. If n = 0.5, it represents Fickian diffusion. If 0.45 < n = 0.89, then the release is controlled by non-Fickian transport. The release is considered zero-order, (case II) transport, if n= 0.89. If n is higher than 0.89, then the diffusion mechanism is a super case II transport [22].
2.5. In Vitro Disc Diffusion Test
Antibacterial activity was carried out against Staphylococcus aureus (ATCC 25923) and Escherichia coli (ATCC 25922) using the agar well diffusion method as described in the British Society for Antimicrobial Chemotherapy (BSAC) Disc Diffusion Method for Antimicrobial Susceptibility Testing, Version 4 (2005) [23]. The testing media used to test the antibacterial activity were Mueller–Hinton agar plates. S. aureus and E. coli were prepared by suspending the bacteria in a saline solution to a suitable inoculum density. A total of 50 µL of the bacterial inoculum was evenly spread across the surface of the agar plates and allowed to dry for a few minutes to ensure proper adherence. Then, 50 µg of BG-V were placed into wells on the agar plates and the plates were incubated at 37 °C for 24 h to allow bacterial growth and interaction with BG-V. After the incubation period, the zone of inhibition (ZOI) surroundings were measured to determine the antibacterial efficacy.
3. Results and Discussion
Figure 2 shows the FTIR of the as-synthesized BG-V (red), vancomycin (black), and BG (blue). The vancomycin spectrum shows peaks at 424, 708, 1013, 1058, 1222, 1394, 1490, 1647, 2094, 2959, and 3265 cm−1 which signify the functional groups of vancomycin, including the amide and hydroxyl stretch around 3265 cm−1, the C=O stretching vibration from the amide bonds around 1647 cm−1, and the C-N stretching and bending vibration peaks in the 1200–1500 cm−1 range [24]. The peaks observed at 2094 and 2959 cm−1 represent the R-NH-R and -CH2-CH3 functional groups, respectively. The BG spectra peaks include 443, 790, 875, 1043, and 1468 cm−1, which signify the characteristics of the silica, phosphate, and carbonate peaks. The peaks observed at 790 and 1043 cm−1 represent the Si-O-Si stretching and bending vibrations that are characteristic of the silicate glass, while the peak observed at 875 represents the P-O bending vibration, and the peak at 1468 represents the carbonate group (CO3−2) [25]. The BG-V spectra show peaks at 432, 797, 1036, 1341, 1416, 1640, and 3399 cm−1, which signify the characteristics of the silica, phosphate, and carbonate peaks similar to the BG spectra. Specifically, the peaks at 1036 and 797 cm−1 represent the Si-O-Si stretching and bending vibrations, characteristic of the silicate glass structures. The broad peak at 3399 cm−1 suggests hydroxyl stretching with a shift of the peak for the BG-V, indicating interactions between the hydroxyl and amide groups. The higher intensity of the peaks observed at 1341 and 1416 cm−1 of the BG-V suggests the integration of vancomycin into the BG pores during synthesis. The peak at 1640 cm−1 suggests retained amide C=O stretching, indicating the maintenance of vancomycin’s integrity within the composite. This is consistent with previous studies which demonstrated the successful incorporation of vancomycin into polymeric carriers like PCL microspheres [26] and mesoporous silica nanoparticles (MSN) [27]. The spectral evidence provided here agrees with the findings of these studies, confirming the integration of vancomycin without chemical degradation.

Figure 2.
FT-IR of vancomycin (black) and BG-V (red) at day 0 and BG (blue). The peaks highlighted represent the functional groups of BG, BG-V, and vancomycin.
Figure 3 shows the XRD patterns of vancomycin and BG-V before and after the drug release studies. The black amorphous pattern represents the glass before immersion in PBS for drug release, while the red pattern shows the crystalline phase after immersion in PBS. The blue pattern shows the vancomycin spectrum which has an amorphous structure with a broad band that starts at ~10.2° and ends around ~38.8°, which was also observed in other studies [28]. The black pattern shows the amorphous BG-V structure with a broad band that starts at ~10° and ends at ~35° that is characteristic of bioactive glass before immersion in PBS [29]. The integration of vancomycin can be observed through the higher intensity of the BG-V pattern as the two broad peaks overlap as observed in Figure 3b, which compares the XRD pattern of BG without vancomycin and BG-V. Figure 3b shows BG-V, which has a broad amorphous peak with an intensity going up to 1127 a.u., while the BG without vancomycin had the highest intensity at 680 a.u.; the intensities were measured starting at the same intensity of 0 a.u., but the figure shows both spectra to clarify the differences between them.

Figure 3.
(a) XRD of vancomycin (blue) and BG-V before drug release in PBS (black) and after drug release studies (red); (b) shows BG-V and BG. The peaks marked with * indicate HA development on the surface of BG-V.
Figure 3a also shows the XRD pattern of BG-V after the drug release (red), which revealed distinct crystalline structures formed on the BG after immersion, signifying the formation of hydroxyapatite (HA) and indicating the degradation of the glass as it releases vancomycin. The development of HA on the surface of BG-V is confirmed by the presence of the following diffraction peaks at θ = 25.9°, 31.6°, 32.2°, 32.7°, and 39.7°, corresponding to the (002), (211), and (310) reflections of the HCA crystals [30].
Hydroxyapatite (HA) is the mineral component of bone and, based on the International Centre for Diffraction Data (ICDF) 09-0432, when detected through XRD different peaks, will appear at 25.87°, 31.77°, 32.19°, 32.9°, and 39.81° representing the (h, k, l) diffraction planes (002), (211), (300), and (310), respectively. Additionally, peaks appearing at θ 45.3°, 46.5°, 49.4°, and 53.2° represent the (203), (222), (213), (004), and (422), respectively [21]. After drug release in PBS, BG-V shows incredible bioactivity, indicating that the glass is biodegrading as it releases the loaded vancomycin in vitro. The deposition of HA on BG-V emphasizes its suitability for bone regeneration and antimicrobial applications, demonstrating its dual function of enhancing bone integration while mitigating bacteria. The bioactivity of BG-V, as observed in the XRD spectra, aligns with previous studies where HA formation on the surface of bioactive glass confirmed bioactivity. This mirrors the findings of Bui et al. (2019) [31], who observed bioactivity on sol–gel (58S) bioactive glass after 2 days, noting that the peaks become sharper with longer soaking time. Further supporting these observations, Anh Tuan et al. (2021) [32], demonstrated that 58S bioactive glass prepared by a hydrothermal, acid-free process developed HA within just 1 day, as shown by two prominent XRD peaks at 26° and 32°, which intensified with prolonged soaking time. These consistent findings across different synthesis methods highlight the HA-forming capability of SiO₂-CaO-P₂O₅ systems and validate BG-V’s surface reactivity. The parallels in XRD patterns between these studies and this study confirm the reliability of the bioactivity assessment performed here.
The nitrogen adsorption–desorption graph shown in Figure 4 represents the BG-V before drug release (black). It is observed that the graph shows a type IV isotherm with no hysteresis, indicating that there is a lower surface area as the pores are blocked by the adsorption of vancomycin onto the BG. The second graph in red shows that after the drug is released, the isotherm observed is type IV with hysteresis, indicating a vertically oriented horn-shaped pore [33]. This shows that following drug release, the pores of BG-V open and the surface area increases; this aids in the gradual release of the vancomycin from the BG as it allows it to release the physically adsorbed drug followed by the entrapped drug that is being held by hydrogen bonds. The development of hydroxyapatite on the surface of BG also contributes to the increase in the surface area, as the silanol layer (Si-OH) is converted into HA.

Figure 4.
Nitrogen adsorption–desorption isotherm of as-synthesized BG loaded with vancomycin before (black) and after (red) drug release studies.
Table 1 presents the data obtained from BET analysis, including surface area, pore volume, and pore size. Measurements were taken both before and after the drug release test to evaluate changes over time. A significant increase in surface area is observed from before the drug release and after. On day 0, the surface area was measured at 20.23 m2/g, which increased to 156.64 m2/g after drug release, suggesting pore opening and drug release. This increase may also indicate the formation of HA on the surface or pore widening due to the biodegradation of BG-V when immersed in PBS.

Table 1.
BET analysis of BG-V at day 0 (BG-V 0 d) before drug release studies and at day 30 (BG-V 30 d) after drug release study.
The results further reveal changes in pore volume. At day 0, the pore volume was recorded at approximately 0.128 cm3/g, increasing to 0.613 cm3/g following the drug release study. This suggests that the release of the drug from the pores contributed to pore expansion, allowing more gas to adsorb on the surface during the second BET analysis.
Pore size measurements, recorded in nanometers, show a shift from 23.27 nm before drug release to 15.05 nm after drug release. This reduction may result from the deposition of HA on the surface, leading to the formation of numerous smaller pores. The reprecipitation of material on the glass surface could explain the simultaneous increase in surface area and decrease in average pore size.
Figure 5 shows the SEM images of the as-synthesized BG-V before and after the drug release studies. The first image (a) shows a smooth and dense surface at day 0, while the second image (b) shows the crystallization of the apatite layer on the surface of the BG. Figure 5b shows an increase in porosity which can be attributed to the degradation of BG as well as the release of the preloaded vancomycin.

Figure 5.
SEM images of BG-V before (a) the drug release study and after (b) the drug release study. Image (b) shows a more porous structure after drug release.
Figure 6 shows the SEM-EDS, which also confirms that the development of HA on the surface of BG-V as a spectrum of atom weight percentage of Si, Ca, and P went from 49.3%, 45%, and 10%, respectively, to 28.5%, 26.5%, and 17.5% after the drug release test was conducted in around 33 days. The ratio of Ca/P was observed to be 1.51 after immersion in PBS, the same ratio reported in other studies indicating the crystallization of apatite on the surface of the BG. The formation of a Ca/P ratio around 1.5 is particularly significant as it closely resembles the stoichiometric ratio found in natural bone minerals, suggesting that the bioactive glass has effectively facilitated the biomimetic mineralization process [34,35]. Furthermore, the SEM-EDS analysis revealed the presence of a newly formed crystalline layer on the surface of the BG-V after immersion in PBS, which indicates the bioactive glass’s capability to promote the deposition of HA. This is consistent with the XRD findings as it shows the crystalline layer that developed on the surface of BG-V after immersion in PBS and provides evidence for the ability of this material to deliver drugs and repair bone defects. These findings align with previous studies, where increased Ca, P, and O concentrations on the bioactive glass surface were shown to indicate HA formation. In a study conducted by Syed Nuzul et al., the Ca/P ratios reported were 1.78, 1.60, and 1.2, confirming HA deposition, with differences attributed to variations in the initial Ca and P content of the glass compositions [36]. Further supporting this, Adams et al. observed HA development on the surface of bioactive glass evidenced by the increase in phosphate and calcium concentrations and a decrease in silicon concentration after immersion in SBF for seven days [37].

Figure 6.
Atomic weight percentage of silicon, calcium, and phosphorous before and after drug release studies.
The drug release studies were conducted in PBS at physiological pH 7.4 to simulate in vivo conditions. Figure 7a shows the drug release observed on day 1, demonstrating a rapid initial release where approximately 20% of the vancomycin was released within the first few hours. This is followed by a plateau phase, indicating that the initial burst corresponds to the release of drug molecules adsorbed on the surface, which occurs within 4 to 5 h.

Figure 7.
Drug release (%) of vancomycin from BG-V for the duration of the experiment (a) and the release on the first day (b) drug release over 30 days.
Figure 7b illustrates the cumulative vancomycin release over 30 days. While the initial phase mirrors the burst release as seen in Figure 5a, the long-term profile reveals a more gradual and sustained release pattern. The near-linear progression of drug release beyond the first day suggests a controlled diffusion mechanism or gradual degradation of the bioactive glass matrix, facilitating continuous drug delivery. This extended release profile is advantageous for maintaining therapeutic levels of vancomycin over extended periods, reducing the need for frequent dosing and enhancing the material’s suitability for applications in infection prevention and bone regeneration.
The data highlight the biphasic nature of drug release, where an initial rapid phase addresses acute therapeutic needs, followed by a sustained release phase that supports prolonged treatment efficacy. This release behaviour is characteristic of bioactive glass systems designed for localized drug delivery, reinforcing their potential in clinical applications.
The drug release data were analyzed using kinetic models to describe the release mechanisms; this was performed following previous studies [22,38]. To assess which model best fits the experimental data, the coefficient of determination (R2) was calculated for each model. The results in Figure 8 show an R2 value of 0.977 for the zero-order model, while the first-order model gave a negative R2 of 0.978. The Higuchi and Korsmeyer–Peppas models had R2 values of 0.967 and 0.978, respectively. The Korsmeyer–Peppas model had the highest R2 value, suggesting that drug release is governed by a combination of diffusion and matrix erosion, which are characteristic of anomalous transport. The Korsmeyer–Peppas model is usually applied to describe drug release from porous materials, where the release mechanism does not follow simple diffusion [39]. An important parameter in this model is the release exponent n, which provides insight into the drug release mechanism. In this study, the calculated n-value was 0.7119, indicating anomalous (non-Fickian) transport [39]. This result implies that drug release is controlled by a combination of diffusion through the matrix and the gradual erosion of the delivery system, aligning with findings from previous research on bioactive glass and polymeric drug delivery systems [40].

Figure 8.
The drug release kinetics models show the goodness of fit for the zero–order model, first–order mode, Korsmeyer–Peppas mode, and Higuchi model.
Biofilm infections require consistent and high concentration when detected on prosthetics because of their extracellular matrix, which impairs drug penetration. Given that the minimum inhibitory concentration (MIC) for S. aureus ranges from 2 to 16 μg/mL [41], biofilm infections require higher concentration and exposure for a longer time, BG-V needs to maintain a much higher concentration for a long period to achieve the complete eradication of biofilms. In this study, BG-V was able to maintain an average of around 229.5 μg/mL daily in vitro which is below the toxic levels identified by Drouet et al. (2015), where they found a significant increase in human umbilical vein endothelial cell death from vancomycin concentrations of 2.5 mg/mL [42]. By maintaining this level of drug release, BG-V ensures the complete elimination of biofilms while simultaneously dissolving to rebuild bone damaged by the infection.
Antimicrobial susceptibility testing was conducted using the agar well diffusion method as shown in Figure 9. Sterilized BG-V samples were placed in wells within the agar to evaluate their antibacterial activity. The experiment was performed in triplicate to ensure the accuracy and reproducibility of the results. The plates were incubated at 37 °C for 24 h, after which the zones of inhibition (ZOI) were measured [43]. Figure 9a shows that the disc diffusion test against S. aureus on Mueller–Hinton agar revealed a ZOI of 27 ± 0.2 mm, indicating a strong antibacterial effect. Similarly, Figure 9b shows that the test against E. coli showed a ZOI of 35 ± 0.4 mm, demonstrating a strong antibacterial effect against this Gram-negative bacterium as well. Figure 9c,d show the negative bioactive glass and positive vancomycin controls, respectively. The negative control shows no measurable ZOI, confirming that the observed effects are not due to the bioactive glass itself, while the positive control inhibited bacterial growth completely, confirming the effectiveness of vancomycin against bacteria. The well-defined circular shape of the ZOI reflects the consistent diffusion of vancomycin from the BG-V, suggesting homogeneity in drug loading and release from the BG-V matrix.
Figure 9.
Disc diffusion of BG-V against (a) S. aurues. It has a zone of inhibition of 2.7 ± 0.2 cm; (b) E. coli with a ZOI of 3.5 ± 0.4 cm; (c) BG as negative control; and (d) vancomycin as positive control.
Figure 10 shows the antibacterial efficacy of BG-V, which was evaluated against S. aureus using a time-dependent bacterial killing assay. A bacterial culture of S. aureus (106 CFU/mL) was treated with BG-V, and samples were withdrawn at 1 h, 5 h, 24 h, and 48 h for plating. The results show a significant reduction in colony counts for BG-V compared to the control. At 24 h, BG-V showed 1400 colonies compared to 5 × 1012 CFU/mL in control. By 48 h, BG-V exhibited a lower colony count, showing the effectiveness of BG-V in killing bacteria. A one-tailed t-test (α = 0.05) comparing the means of the BG-V and control group revealed a statistically significant difference in bacterial growth after 1 h (p < 0.05). The same test shows that at 5, 24, and 48 h, BG-V treatment resulted in significant log reductions of 3.73, 9.55, and 10.18, respectively (p < 0.001), demonstrating its antibacterial effect over time. This time-dependent antibacterial activity highlights the potential of BG-V for localized antibiotic delivery in biomedical applications.

Figure 10.
Bacterial killing assay comparing the control group to BG-V at 1 h, 5 h, 24 h, and 48 h. The figure shows the log bacterial growth of the control group compared to BG-V. The statistical difference is indicated by the *, where * shows that the p < 0.05, while *** shows that p < 0.001. The data are presented as mean ± standard deviation and all the experiments were performed in triplicates.
4. Conclusions
This study investigates bioactive glass preloaded with vancomycin (BG-V) as a novel drug delivery system designed for long-term antibiotic delivery. BG-V was synthesized using a chemistry-based sol–gel method, where a vancomycin solution was prepared and mixed with different metal oxides, followed by overnight stirring. The mixture was then dried at room temperature to produce the final BG-V powder, which was used without further modifications. Fourier-transform infrared spectroscopy confirmed the successful incorporation of vancomycin into the BG-V structure. Scanning electron microscopy revealed a smaller surface area and blocked pores, indicating that vancomycin was entrapped within the BG-V. By the end of drug release studies, changes in surface area and BJH analysis showed an increase in surface area and the opening of pores post-release. In vitro drug release studies demonstrated an initial slight burst release, with approximately 20% of the drug released on the first day, followed by a steady release until the end of the experiment. The analysis of the drug release data using various kinetic models revealed that BG-V follows the Korsmeyer–Peppas model, suggesting that the drug was released through a combination of diffusion and matrix degradation. A disc diffusion test against S. aureus on Mueller–Hinton agar showed a zone of inhibition (ZOI) of 35 ± 0.2 mm, indicating a strong antibacterial effect. Furthermore, the investigation of the bacterial killing ability of BG-V demonstrated significant log reductions in bacterial growth after 5, 24, and 48 h, with values of 3.73, 9.55, and 10.176, respectively. These results highlight the substantial reduction in bacterial growth achieved with the application of BG-V.
Author Contributions
Conceptualization, D.A. and Y.D.; methodology, D.A.; software, D.A.; validation, D.A. and Y.D.; formal analysis, D.A.; investigation, D.A.; resources, Y.D.; data curation, D.A.; writing—original draft preparation, D.A.; writing—review and editing, Y.D.; visualization, D.A.; supervision, Y.D. All authors have read and agreed to the published version of the manuscript.
Funding
This research received no external funding.
Institutional Review Board Statement
Not applicable.
Informed Consent Statement
Not applicable.
Data Availability Statement
The raw data supporting the conclusions of this article will be made available by the authors on request.
Acknowledgments
Figures have been produced using OriginPro Software (OriginLab Corporation, 2025 10.2, Education edition).
Conflicts of Interest
The authors declare no conflicts of interest.
Abbreviations
- The following abbreviations are used in this manuscript:
| BET | Braunauer–Emmett–Teller; |
| BG-V | Bioactive glass preloaded with vancomycin; |
| BJH | Barrett, Joyner, and Halenda; |
| CMC | Critical micelle concentrations; |
| FTIR | Fourier-transform infrared spectroscopy; |
| HCA | Hydroxyapatite; |
| HCl | Hydrochloric acid; |
| ICP-OES | Induced Coupled Optical Emission Spectroscopy Plasma; |
| MBG | Mesoporous bioactive glass; |
| NBO | Non-bridging oxygens; |
| SBF | Simulated body fluid; |
| SDA | Surface-directing agents; |
| SEM | Scanning electron microscopy; |
| XRD | X-ray diffraction; |
| ZOI | Zone of inhibition |
References
- Hench, L.L. The story of Bioglass. J. Mater. Sci. Mater. Med. 2006, 17, 967–978. [Google Scholar] [CrossRef]
- Li, R.; Clark, A.E.; Hench, L.L. An investigation of bioactive glass powders by sol-gel processing. J. Appl. Biomater. 1991, 2, 231–239. [Google Scholar] [CrossRef] [PubMed]
- Brunner, T.J.; Grass, R.N.; Stark, W.J. Glass and bioglass nanopowders by flame synthesis. Chem. Commun. 2006, 13, 1384–1386. [Google Scholar] [CrossRef] [PubMed]
- Jones, J.R. Review of bioactive glass: From Hench to hybrids. Acta Biomater. 2013, 9, 4457–4486. [Google Scholar] [CrossRef]
- Zheng, Y.; Xiong, C.; Zhang, D.; Zhang, L. In vitro bioactivity evaluation of α-calcium sulphate hemihydrate and bioactive glass composites for their potential use in bone regeneration. Bull. Mater. Sci. 2018, 41, 59. [Google Scholar] [CrossRef]
- Lin, C.; Huang, L.C.; Shen, P. Na2CaSi2O6–P2O5 Based Bioactive Glasses. Part 1: Elasticity and Structure. J. Non-Cryst. Solids 2005, 351, 3195–3203. [Google Scholar] [CrossRef]
- Sepulveda, P.; Jones, J.R.; Hench, L.L. Characterization of melt-derived 45S5 and sol-gel-derived 58S bioactive glasses. J. Biomed. Mater. Res. 2001, 58, 734–740. [Google Scholar] [CrossRef]
- Vallet-Regi, M.; Acros, D. Bioactive Glasses: Properties, Composition and Recent Applications; Nova Science: Madrid, Spain, 2020. [Google Scholar]
- Ksouri, D.K.; Khiereddine, H.; Aksas, A.; Bir, F.; Slimani, N.; Santos, J. Synthesis of ternary bioactive glass derived aerogel and xerogel: Study of their structure and bioactivity. Nova Biotechnol. Chim. 2018, 17, 150–159. [Google Scholar] [CrossRef]
- Araújo, M.; Miola, M.; Baldi, G.; González, J.; Verné, E. Bioactive glasses with low ca/p ratio and enhanced bioactivity. Materials 2016, 9, 226. [Google Scholar] [CrossRef]
- Mukundan, L.M.; Nirmal, R.; Vaikkath, D.; Nair, D. A new synthesis route to high surface area sol gel bioactive glass through alcohol washing. Biomatter 2013, 3, e24288. [Google Scholar] [CrossRef]
- Sudipta; Mishra, S.; Murugavel, S. Biomineralization behavior of ternary mesoporous bioactive glasses stabilized through ethanol extraction process. J. Non-Cryst. Solids 2022, 589, 121630. [Google Scholar] [CrossRef]
- Almasri, D.; Dahman, Y. Prosthetic Joint Infections: Biofilm Formation, Management, and the Potential of Mesoporous Bioactive Glass as a New Treatment Option. Pharmaceutics 2023, 15, 1401. [Google Scholar] [CrossRef] [PubMed]
- Wang, F.; Zhou, H.; Olademehin, O.P.; Kim, S.J. Insights into key interactions between vancomycin and bacterial cell wall structures. ACS Omega 2018, 3, 37–45. [Google Scholar] [CrossRef]
- Post, V.; Wahl, P.; Richards, R.G.; Moriarty, T. Vancomycin displays time-dependent eradication of mature staphylococcus aureus biofilms. J. Orthop. Res. 2016, 35, 381–388. [Google Scholar] [CrossRef]
- Anand, A.; Das, P.; Nandi, S.K.; Kundu, B. Development of antibiotic loaded mesoporous bioactive glass and its drug release kinetics. Ceram. Int. 2020, 46, 5477–5483. [Google Scholar] [CrossRef]
- Xia, W.; Chang, J. Well-ordered mesoporous bioactive glasses (MBG): A promising bioactive drug delivery system. J. Control. Release 2006, 110, 522–530. [Google Scholar] [CrossRef]
- Schäfer, M.; Schneider, T.R.; Sheldrick, G.M. Crystal structure of Vancomycin. Structure 1996, 4, 1509–1515. [Google Scholar] [CrossRef]
- Deshmukh, K.; Kovářík, T.; Křenek, T.; Docheva, D.; Stich, T.; Pola, J. Recent advances and future perspectives of sol–gel derived porous bioactive glasses: A review. RSC Adv. 2020, 10, 33782–33835. [Google Scholar] [CrossRef]
- Bruschi, M.L. Modify the Drug Release from Pharmaceutical Systems; Woodhead Publishing: Sawston, UK, 2015. [Google Scholar]
- England, C.G.; Miller, M.C.; Kuttan, A.; Trent, J.O.; Frieboes, H.B. Release kinetics of paclitaxel and cisplatin from two and three layered gold nanoparticles. Eur. J. Pharm. Biopharm. 2015, 92, 120–129. [Google Scholar] [CrossRef]
- Dash, S.; Murthy, N.P.; Nath, L.; Chowdhury, P. Kinetic modeling on drug release from controlled drug delivery systems. Acta Pol. Pharm. 2010, 67, 217–223. [Google Scholar]
- Andrews, J. 2005 BSAC standardized disc susceptibility testing method (version4). J. Antimicrob. Chemother. 2005, 56, 60–76. [Google Scholar] [CrossRef] [PubMed]
- Sun, J.; Li, J.; Fan, H.; Ai, S. Ag nanoparticles and vancomycin comodified layered double hydroxides for simultaneous capture and disinfection of bacteria. J. Mater. Chem. B 2013, 1, 5436–5442. [Google Scholar] [CrossRef]
- Auniq, R.; Boonyang, U.; Hirun, N. Three-Dimensionally Ordered Macroporous-Mesoporous Bioactive Glass Ceramics for Drug Delivery Capacity and Evaluation of Drug Release. In Ceramic Materials; IntechOpen: London, UK, 2020. [Google Scholar]
- Zhou, J.; Fang, T.; Wen, J.; Shao, Z.; Dong, J. Silk coating on poly(ε-caprolactone) microspheres for the delayed release of vancomycin. J. Microencapsul. 2011, 28, 99–107. [Google Scholar] [CrossRef] [PubMed]
- Memar, M.Y.Y.; Mina, Y.; Farajnia, S.; Moghaddam, F. Antibacterial and biofilm-inhibitory effects of vancomycin-loaded mesoporous silica nanoparticles on methicillin-resistant staphylococcus aureus and gram-negative bacteria. Arch. Microbiol. 2023, 205, 109. [Google Scholar] [CrossRef] [PubMed]
- Rahaman, S.N.; Ayyadurai, N.; Anandasadagopan, S.K. Synergistic effect of vancomycin and gallic acid loaded MCM-41 mesoporous silica nanoparticles for septic arthritis management. J. Drug Deliv. Sci. Technol. 2023, 82, 104353. [Google Scholar] [CrossRef]
- Schumacher, M.; Habibovic, P.; van Rijt, S. Mesoporous Bioactive Glass Composition Effects on Degradation and Bioactivity. Bioact. Mater. 2021, 6, 1921–1931. [Google Scholar] [CrossRef]
- Tabassum, S.; Saqib, M.; Batool, M.; Sharif, F.; Gilani, M.A.; Huck, O. Eco-friendly synthesis of mesoporous bioactive glass ceramics and functionalization for drug delivery and hard tissue engineering applications. Biomed. Mater. 2024, 19, 035014. [Google Scholar] [CrossRef]
- Bui, X.V.; Dang, H.T. Bioactive glass 58S prepared using an innovation sol-gel process. Process. Appl. Ceram. 2019, 13, 98–103. [Google Scholar] [CrossRef]
- Anh Tuan, T.; Guseva, E.V.; Anh, N.; Dat, H.T. Simple and Acid-Free Hydrothermal Synthesis of Bioactive Glass 58SiO2-33CaO-9P2O5 (wt%). Crystals 2021, 11, 283. [Google Scholar] [CrossRef]
- Baldovino-Medrano, V.G.; Niño-Celis, V.; Isaacs-Giraldo, R. Systematic analysis of the nitrogen adsorption-desorption isotherms recorded for a series of microporous—Mesoporous amorphous aluminosilicates using classical methods. J. Chem. Eng. Data 2023, 68, 2512–2528. [Google Scholar] [CrossRef]
- Santhiya, D.; Alajangi, H.K.; Anjum, F.; Murugavel, S.; Ganguli, M. Bio-inspired synthesis of microporous bioactive glass-ceramic using CT-DNA as a template. J. Mater. Chem. B 2013, 1, 6329–6338. [Google Scholar] [CrossRef] [PubMed]
- Zheng, K.; Boccaccini, A.R. Sol-gel processing of bioactive glass nanoparticles: A review. Adv Colloid Interface Sci. 2017, 249, 363–373. [Google Scholar] [CrossRef]
- Nuzul, S.F.S.; Zainuddin, F.; Osman, A.F.; Mohamad, H. Physical Characteristic and In-Vitro Bioactivity Property of Sintered Glasses made via Sol-Gel and Powder Sintering Process. Adv. Sustain. Technol. (ASET) 2024, 1, 42–51. [Google Scholar]
- Adams, L.A.; Essien, E.R.; Adesalu, T.A.; Julius, M.L. Bioactive Glass 45S5 from Diatom Biosilica. J. Sci. Adv. Mater. Devices 2017, 2, 476–482. [Google Scholar] [CrossRef]
- Costa, P.; Lobo, J.M.S. Modeling and comparison of dissolution profiles. Eur. J. Pharm. Sci. 2001, 13, 123–133. [Google Scholar] [CrossRef]
- Siepmann, J.; Peppas, N.A. Modeling of drug release from delivery systems based on hydroxypropyl methylcellulose (HPMC). Adv. Drug Deliv. Rev. 2001, 48, 139–157. [Google Scholar] [CrossRef] [PubMed]
- Peppas, N.A.; Narasimhan, B. Mathematical models in drug delivery: How modeling has shaped the way we design new drug delivery systems. J. Control. Release 2014, 190, 75–81. [Google Scholar] [CrossRef] [PubMed]
- Aminzadeh, Z.; Yadegarynia, D.; Fatemi, A.; Dehkordi, E.T.; Armaki, S.A. Vancomycin Minimum Inhibitory Concentration for Methicillin-Resistant Staphylococcus aureus Infections; Is There Difference in Mortality Between Patients? Jundishapur J. Microbiol. 2014, 7, e12831. [Google Scholar] [CrossRef]
- Drouet, M.; Chai, F.; Barthélémy, C.; Lebuffe, G.; Debaene, B.; Décaudin, B.; Odou, P. Influence of Vancomycin Infusion Methods on Endothelial Cell Toxicity. Antimicrob. Agents Chemother. 2015, 59, 930–934. [Google Scholar] [CrossRef]
- Ranga, N.; Poonia, E.; Jakhar, S.; Sharma, A.K.; Kumar, A.; Devi, S.; Duhan, S. Enhanced antimicrobial properties of bioactive glass using strontium and silver oxide nanocomposites. J. Asian Ceram. Soc. 2019, 7, 75–81. [Google Scholar] [CrossRef]
Disclaimer/Publisher’s Note: The statements, opinions and data contained in all publications are solely those of the individual author(s) and contributor(s) and not of MDPI and/or the editor(s). MDPI and/or the editor(s) disclaim responsibility for any injury to people or property resulting from any ideas, methods, instructions or products referred to in the content. |
© 2025 by the authors. Licensee MDPI, Basel, Switzerland. This article is an open access article distributed under the terms and conditions of the Creative Commons Attribution (CC BY) license (https://creativecommons.org/licenses/by/4.0/).